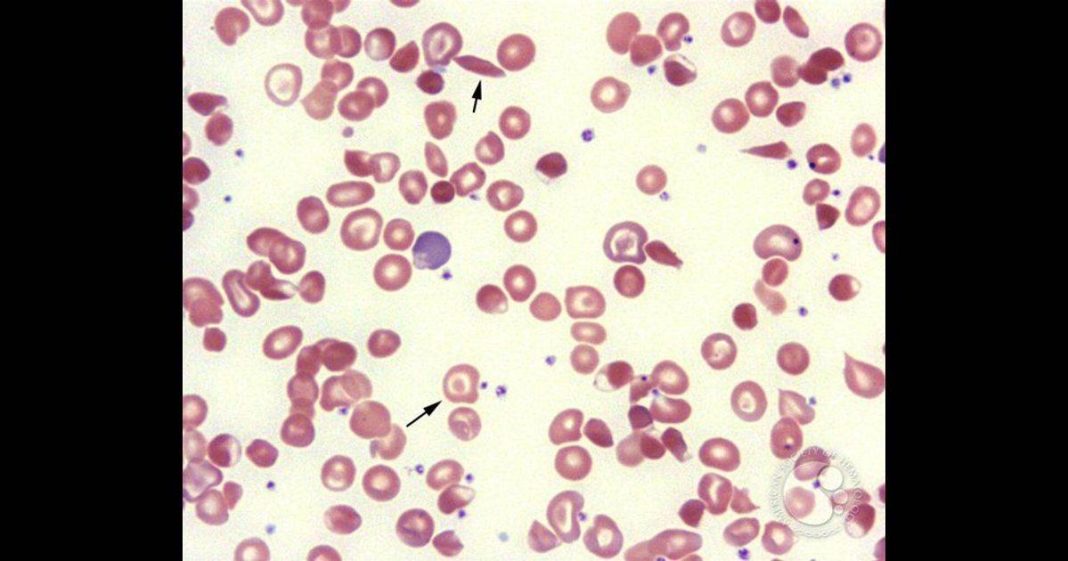

Beta Thalassemia is a special type of Anemia that can be transmitted from parents to their offspring. According to a survey 7 out of every hundred people in Pakistan have at least one defective gene which makes them the carrier of beta Thalassemia. This disease is actually due to a defect in the formation of the protein Haemoglobin which fills our red blood cells and carries oxygen to all parts of our body. The hemoglobin molecule has two beta and two alpha chains.
The formation of these beta chains is under the control of two genes. If one of the genes is defective then the person is called a carrier or trait but if two genes are defective the disease manifests as Thalassemia major. Carrier state goes unnoticed many times as these individuals have just mild symptoms of anemia like pale skin, easy fatiguability and low energy and they never get any investigations. When two such individuals join together to raise a family then there is a 25% chance at each conception that the baby will be born as thalassemia major, 50% chance that the baby will be carrier which might again go unnoticed and 25% chance that the newborn will not inherit the defective beta gene.
Read more: DPO for a Day: Child Thalassemia Patient’s wish Fulfilled
What are the signs we should be aware of?
Babies born with Thalassemia major will start showing signs of delayed growth, pale skin, joint pains and usually get diagnosed by 2 years of life. Their red blood cells carry less oxygen to all parts of the body and get destroyed easily. As a result their liver and kidneys also get overburdened. Blood transfusions are started to meet the demands of the body but with frequent blood transfusions come the additional problems of infections and transfusion reactions. Moreover, iron from blood transfusions starts getting deposited in the liver, heart, brain etc and impairs the function of all these organs. The average life expectancy is calculated to be 25-35 years.
The birth of a child with Thalassemia major can be prevented primarily by getting the carrier status checked for the population in general. Like Pakistan, Middle-Eastern countries also have a high rate of this disease but those countries have a protocol called “ Premarital screening” in which they screen the couples for inheritable diseases.
In Pakistan, we have the Thalassemia foundations in all big cities but generally, there is no concept of pre-marital screening. Inter-cousin marriages are still popular which favours defective genes of a family to cluster and present as a continuation of diseases as part of the inheritance.
Once a carrier mother goes to her routine pregnancy evaluation, she gets diagnosed to have anemia, which usually is treated as the most common Iron deficiency anemia. Further investigations are done only if her anemia remains unresolved. Till that time the chances of having a thalassemia major baby in the womb are unknown. Even if both parents are known to be carriers, at the outset the options are not very easily accessible. They can either rely on the random chances mentioned above or opt to get the baby tested while still in the womb. This requires complicated tests to get some fluid from around the baby by passing a needle through the mother’s abdomen.
Read more: PM Khan to launch Naya Pakistan Health Card in Islamabad
That fluid is then analyzed and the beta genes of the baby mapped. This knowledge does not give much relief as the majority will still carry on with their pregnancy. Other options could be to avail test tube baby through IVF, which allows the gene testing on newly formed embryos before returning those to the mother’s womb. This process may be in conflict with cultural and religious beliefs whereby selective embryo transfer can be regarded as an interference with the will of the creator. In some other countries, couples may even decide to go for sperm donation to avoid passing on an inheritable disease.
Important facts that everyone should know
There is a blood test that is done very commonly to assess anemia and infection whenever someone presents to a clinic or hospital. That test is the Full Blood Count also known as FBC or Complete blood Count, i.e CBC. It tells us about the number of red blood cells an individual is carrying, The content of the protein Haemoglobin, the size of red blood cells, the content of hemoglobin in red blood cells, etc. It should be a routine for all Laboratories to just do one additional calculation each time they report the result of FBC/CBC. That additional test is the Mentzer index.
This is a ratio of the average size of red blood cells divided by the number of red blood cells in the report. This is a quick way to differentiate between iron deficiency anemia and Beta-thalassemia. Further testing can be done at specialized centers which can be costly and unavailable as well. In this way, more people will become aware of their Thalassemia carrier state.
Read more: Youth should do blood donation for personal and communal benefits, expert
Primary prevention by premarital screening and self-awareness can be a way of avoiding transmission of inheritable diseases but it might sound far from the romantic associations which bring couples together to enter a marital bond. They may still decide to rely on the ¾ odds of not having a beta major baby, which might increase to ½ if a carrier cohabits with a beta major.
I hope this overview helps to understand the basics of Beta-thalassemia.
The author has done MBBS, MCPS, FCPS, MCCEE, and is a consultant Obstetrician & Gynecologist at Mega Medical Complex. The views expressed in the article are the author’s own and do not necessarily reflect the editorial policy of Global Village Space.